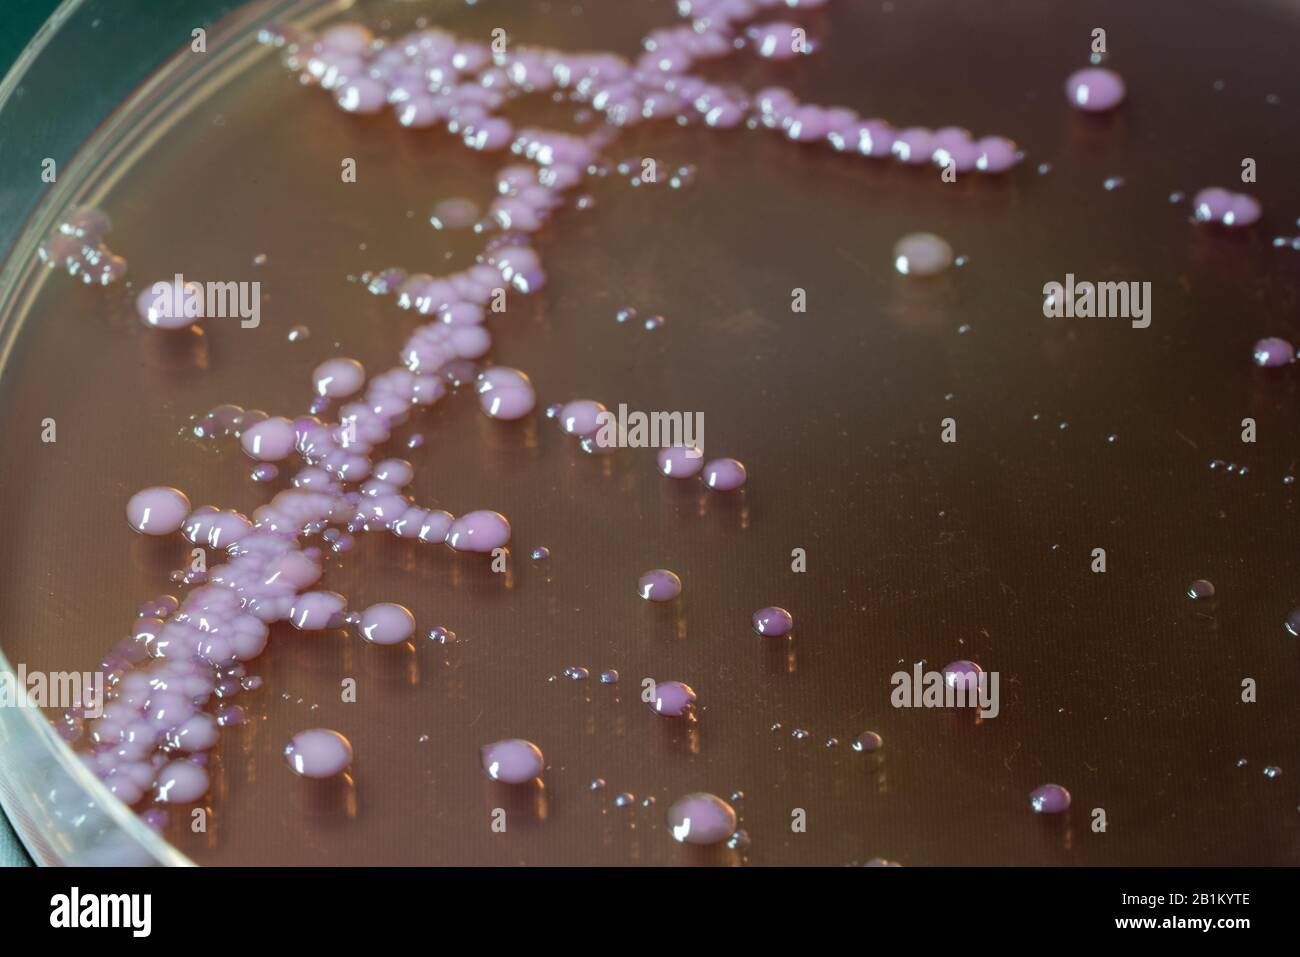
Bakterienkolonien auf der mittleren Petrischildplatte mit MacConkey

Myrsini Koloni –en griego, Μυρσίνη Κολώνη– (18 de noviembre de 1979) es una deportista griega que compitió en lucha libre. Ganó una medalla de bronce en el Campeonato Europeo de Lucha de 2004, en la categoría de 48 kg.[1]
Palmarés internacional
Referencias